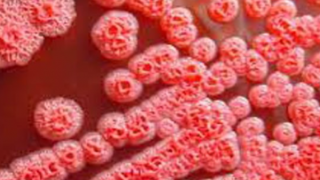
Đắk Lắk ghi nhận trường hợp thứ 2 mắc bệnh Whitmore

2 ca bệnh nhiễm “vi khuẩn ăn thịt người” ở Đắk Lắk sắp xuất viện
Ngày 10/7, thông tin từ Sở Y tế Đắk Lắk cho biết, trên địa bàn tỉnh vừa ghi nhận 2 bệnh nhân mắc bệnh Whitmore - thường gọi là nhiễm vi khuẩn ăn thịt người. Đây cũng là 2 ca bệnh đầu tiên phát hiện trên địa bàn tỉnh Đắk Lắk trong năm 2025.
Trường hợp đầu tiên là bệnh nhân B.I.C. (Nam, SN 1970, trú tại thôn Hiệp Đoàn, xã Ea M’Đroh, tỉnh Đắk Lắk). Theo người nhà bệnh nhân, vào ngày 11/6, ở nhà bệnh nhân xuất hiện các triệu chứng sốt cao liên tục, khó thở kèm ho có đờm. Từ ngày 18/6 đến 23/6, bệnh nhân đi khám, điều trị tại Trung tâm Y tế Buôn Đôn với chẩn đoán suy hô hấp cấp, viêm phổi nặng, đái tháo đường type 2, tổn thương thận cấp, viêm khớp háng(T), cơn đau thắt ngực, tăng mỡ máu. Ngày 23/6, bệnh nhân nhập viện điều trị tại Bệnh viện Đa khoa vùng Tây Nguyên với chẩn đoán viêm phổi nặng, đái tháo đường type 2, tăng huyết áp. Ngày 2/7, bệnh nhân có kết quả xét nghiệm vi sinh dương tính với vi khuẩn Burkholderia pseudomallei.
Trường hợp thứ 2 là bệnh nhân D.L.M. (Nam, SN 1960, trú tại thôn Quảng Đông, xã Hòa Sơn, tỉnh Đắk Lắk). Ngày 14/6, khi ở nhà bệnh nhân có triệu chứng sốt, tiểu buốt. Ngày 24/6, bệnh nhân đi khám, nhập Bệnh viện Đa khoa Vùng Tây Nguyên với chẩn đoán bí tiểu do phì đại tiền liệt tuyến, tăng huyết áp. Ngày 30/6, bệnh nhân có kết quả xét nghiệm vi sinh dương tính với vi khuẩn Burkholderia pseudomallei.

Bác sĩ H’Nuen Hđớk, Phó trưởng khoa Phụ trách Khoa Truyền nhiễm, Bệnh viện Đa khoa vùng Tây Nguyên cho biết, sau khi tiếp nhận 2 bệnh nhân mắc bệnh Whitmore, bệnh viện đã tiến hành điều trị cho các bệnh nhân theo phác đồ của Bộ Y tế. Hiện tại, sức khỏe 2 bệnh nhân đã dần ổn định. Dự kiến trong 5 ngày tới, 2 bệnh nhân sẽ được xuất viện.
Bệnh Whitmore là một bệnh nhiễm trùng ở người và động vật do vi khuẩn Burkholderia pseudomallei gây ra. Vi khuẩn sống trong đất, nước bị nhiễm khuẩn và xâm nhập vào cơ thể người chủ yếu qua các vết thương ở da, niêm mạc, bệnh thường gặp ở các nước khu vực Đông Nam Á.

 Nhiễm khuẩn cấp do bệnh Whitmore có thể gây mất mạng trong 1 tuần
Nhiễm khuẩn cấp do bệnh Whitmore có thể gây mất mạng trong 1 tuần  Đắk Lắk ghi nhận bé gái mắc bệnh Whitmore
Đắk Lắk ghi nhận bé gái mắc bệnh Whitmore Đắk Lắk ghi nhận trường hợp thứ 2 mắc bệnh Whitmore
Đắk Lắk ghi nhận trường hợp thứ 2 mắc bệnh Whitmore